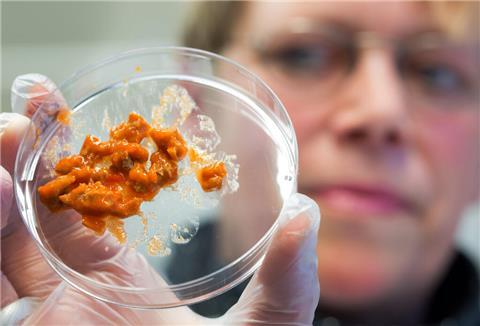

In dem China-Restaurant haben Kontrolleure erhebliche Hygienemängel festgestellt (Symbolbild).
Foto: Colourbox
Einfach ekelhaft: Schimmel, Fett und Gestank in Bremerhavener China-Restaurant
Ein Bremerhavener China-Restaurant ist bei einer Kontrolle durch den Lebensmittelüberwachungs-, Tierschutz- und Veterinärdienst des Landes Bremen (LMTVet) durchgefallen.
Ekel-Alarm in Bremerhavener China-Restaurant
Klebrige Anhaftungen, Schwarzschimmel und undefinierbare Flüssigkeiten: Das sind nur einige der Mängel, die Kontrolleure des LMTVet in einem China-Restaurant in Bremerhaven festgestellt haben.
Im Protokoll, das online einsehbar ist, heißt es: „Der Fußboden im Spülbereich wies teilweise beschädigte Fliesen (...) auf und war großflächig von ausgewaschenen Fugen versehen. In diesen Zwischenräumen sammelten sich Lebensmittelreste, Fettablagerungen und undefinierbare Flüssigkeiten an.“
Und weiter: „Ein unangenehmer, stark fauliger Geruch war in Fußbodennähe in der gesamten Spülecke wahrnehmbar.“
Schwarzschimmel macht sich in der Küche breit
Doch damit nicht genug. An mehreren Stellen fanden die Kontrolleure Schwarzschimmel. „Die Spülmaschine war im Inneren mit rötlichen Anhaftungen und Schwarzschimmel versehen.“
Auch in den Kühleinheiten hatte es sich der Schwarzschimmel schon gemütlich gemacht. „Die Kühlschubladen waren vor allem an den Dichtungsgummis massiv mit Schwarzschimmel behaftet.“
Das Schlimmste: In diesen Schubladen wurden laut Kontrolleuren unter anderem Fleisch und Ananas in verschiedenen Behältern ohne Abdeckung aufbewahrt - unmittelbar an den mit Schimmel behafteten Gummis.
Mängel bei der zweiten Nachkontrolle behoben
Wie in solchen Fällen üblich, hatte das Restaurant daraufhin bis zur Nachkontrolle Zeit, die Mängel zu beheben. Das geschah laut Protokoll auch. „Die Hygienemängel waren nach der zweiten Nachkontrolle am 20. Juni 2024 abgestellt.“
Ekel-Alarm in Bremerhavener China-Imbiss: Hier wird selbst Kontrolleuren schlecht